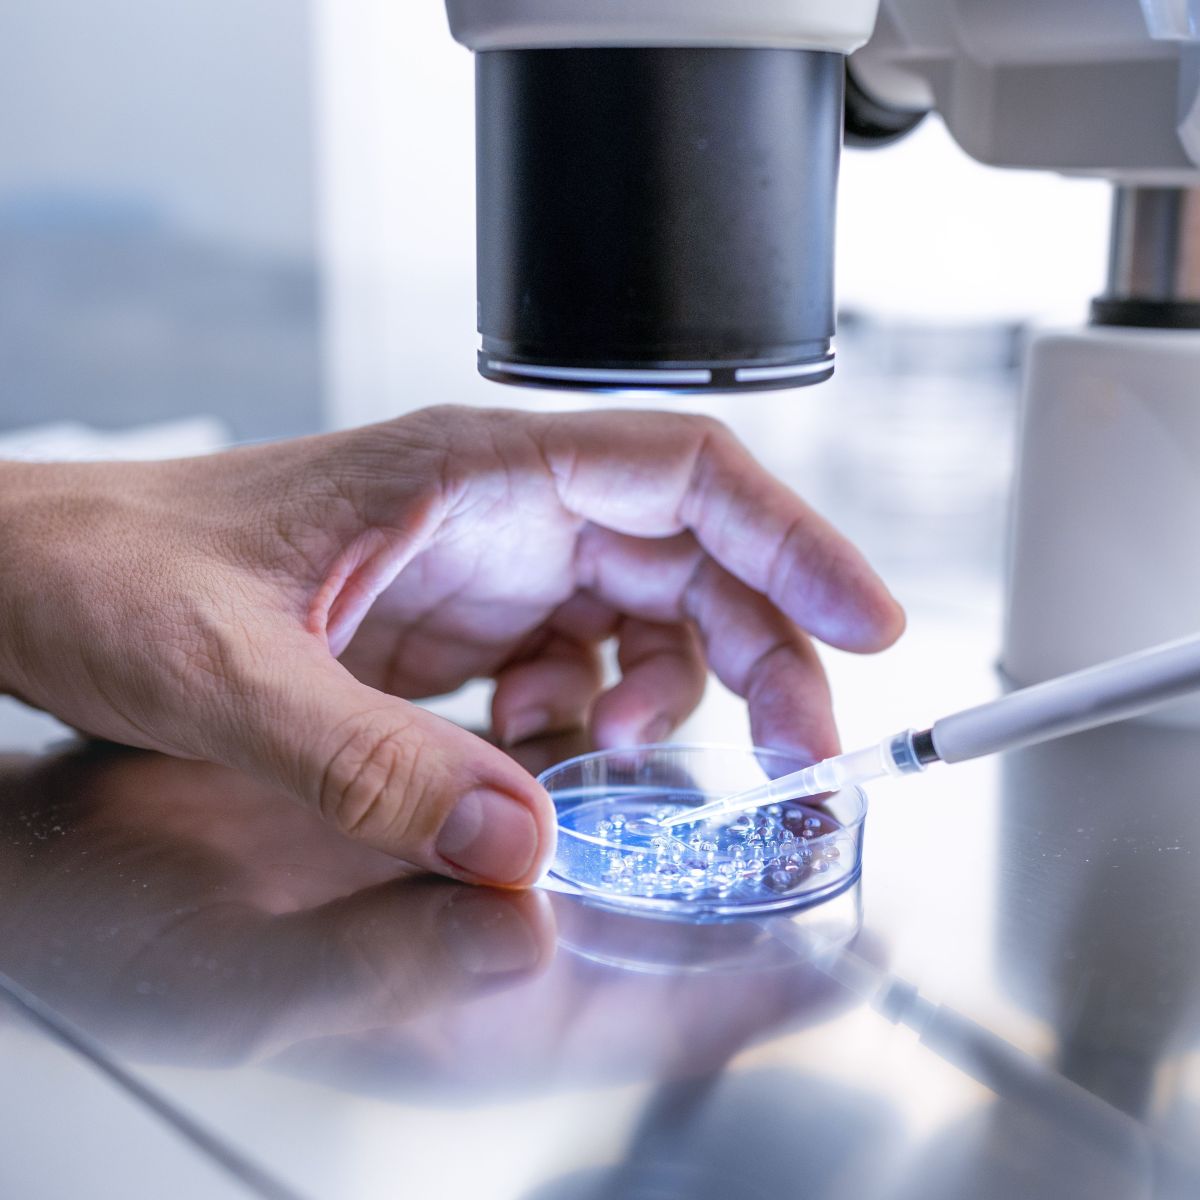
Requisitos para ser uma doadora de óvulos no Brasil

O sonho da Maternidade e Doação de Óvulos em 2026 pode parecer complexo, mas a jornada é mais clara do que você imagina. Muitas mulheres se deparam com obstáculos que parecem intransponíveis, mas a verdade é que a ciência e as regulamentações atuais oferecem caminhos seguros e éticos. Neste guia, eu vou te mostrar como a doação de óvulos funciona na prática, desmistificando o processo e abrindo portas para a maternidade. Fica tranquila, a gente vai desbravar isso juntos.
Como a Maternidade e Doação de Óvulos se Tornam Realidade com Segurança e Ética no Brasil?
A doação de óvulos no Brasil segue regras bem definidas pelo Conselho Federal de Medicina. Isso garante um processo seguro para todos os envolvidos. A lei é clara: a mãe é quem gesta e dá à luz, independentemente da origem do óvulo. Esse é um ponto fundamental para a tranquilidade de quem busca a maternidade por esse caminho.
A doação, por aqui, é sempre anônima e feita de forma altruísta. Ou seja, nada de negociações ou comércios. Essa proteção legal e ética é um dos pilares do programa. Você não precisa se preocupar com transações financeiras diretas.
E olha que interessante: a epigenética mostra como o ambiente da gestante influencia os genes do óvulo. Ou seja, a conexão mãe-bebê vai muito além do material genético inicial. O útero materno tem um papel ativo no desenvolvimento do seu filho.
“O custo médio de uma fertilização in vitro (FIV) com óvulos doados no Brasil varia entre R$ 35.000 e R$ 60.000, conforme dados de clínicas especializadas.”

Doação de Óvulos: Seu Guia Completo para a Maternidade em 2026
A jornada para a maternidade em 2026 pode apresentar caminhos diversos, e a doação de óvulos, também conhecida como ovodoação, surge como uma esperança concreta para muitas mulheres e casais. Este procedimento de reprodução assistida é uma ferramenta poderosa que permite a realização do sonho de ter um filho, mesmo quando a fertilidade natural enfrenta desafios.
No Brasil, a ovodoação é um processo minuciosamente regulamentado, garantindo segurança e ética para todas as partes envolvidas. O Conselho Federal de Medicina (CFM) estabelece as diretrizes que asseguram que a doação seja feita de forma responsável e com o bem-estar de todos como prioridade. Entender cada etapa, desde os requisitos para doar até o processo de fertilização, é fundamental para quem considera esse caminho.
| Aspecto | Detalhes |
|---|---|
| Regulamentação | Rigorosamente supervisionada pelo CFM. |
| Natureza da Doação | Anônima e altruísta; proibido caráter comercial. |
| Maternidade Legal | Garantida à mulher que gesta e dá à luz. |
| Faixa Etária da Doadora | Geralmente entre 18 e 35 anos. |
| Indicações para Receptoras | Menopausa precoce, baixa reserva ovariana, falhas em FIV, casais homoafetivos masculinos. |
| Modelos de Doação | Altruísta e Compartilhada. |
| Custo Médio FIV com Óvulos Doados | R$ 35.000 a R$ 60.000. |

Aspectos Legais e Regulamentação da Ovodoação no Brasil
A ovodoação no Brasil opera sob um arcabouço legal estrito, definido pelo Conselho Federal de Medicina (CFM). Essas normas visam garantir que o processo seja ético, seguro e transparente. É essencial compreender que a legislação brasileira protege a figura da mãe legal como a mulher que carrega a gestação e o parto, independentemente da origem genética do óvulo. Isso confere uma segurança jurídica crucial para quem busca a maternidade por meio desta técnica.
O caráter anônimo e altruísta da doação é um pilar fundamental. A legislação proíbe explicitamente qualquer tipo de comercialização ou compensação financeira direta pela doação de gametas. A relação entre doadora e receptora é mediada pela clínica de reprodução assistida, assegurando que os princípios de solidariedade e responsabilidade sejam mantidos, em conformidade com as diretrizes do CFM.

Quem Pode Doar Óvulos: Critérios e Requisitos
Para se tornar uma doadora de óvulos, é necessário atender a critérios rigorosos que visam garantir a saúde e a segurança do processo. Geralmente, as doadoras são mulheres com idade entre 18 e 35 anos. Essa faixa etária é escolhida porque, nesse período, a qualidade e a quantidade dos óvulos tendem a ser ideais para a reprodução assistida, maximizando as chances de sucesso da fertilização.
Além da idade, a doadora precisa ter uma boa reserva ovariana, o que significa ter uma quantidade satisfatória de óvulos disponíveis. Para confirmar isso, são realizados exames específicos. A saúde geral da doadora também é avaliada através de um check-up completo, incluindo exames para rastreio de doenças infecciosas e genéticas, assegurando que os óvulos estejam livres de quaisquer condições que possam afetar o embrião ou a futura criança.

Quem Pode Receber Óvulos: Indicações e Casos Específicos
A doação de óvulos oferece caminhos para diversas situações em que a gravidez natural é inviável ou apresenta riscos elevados. Mulheres que enfrentam a menopausa precoce, uma condição em que os ovários deixam de funcionar antes dos 40 anos, encontram na ovodoação uma oportunidade de engravidar. Da mesma forma, aquelas com baixa reserva ovariana, mesmo antes da menopausa, podem se beneficiar significativamente.
Pacientes que tiveram falhas em ciclos anteriores de Fertilização In Vitro (FIV), onde os óvulos próprios não resultaram em gestação, também são fortes candidatas. Além disso, a ovodoação é uma solução vital para casais homoafetivos masculinos. Nesses casos, os óvulos doados são fertilizados com espermatozoides do parceiro e o embrião resultante é transferido para um útero de substituição (barriga de aluguel), permitindo que ambos os pais tenham vínculo genético com a criança.

Modelos de Doação de Óvulos: Altruísta e Compartilhada
Existem duas abordagens principais para a doação de óvulos no Brasil: a doação altruísta e a doação compartilhada. Na doação altruísta, a doadora não arca com os custos diretos do tratamento de reprodução assistida. Ela doa seus óvulos por um ato de solidariedade, e os custos são cobertos pela receptora ou pelo casal receptor. Este modelo reforça o caráter não comercial da doação.
Já a doação compartilhada surge como uma alternativa para tornar o tratamento mais acessível. Nesse modelo, a mulher que precisa de óvulos para sua FIV também doa parte de seus próprios óvulos para outra paciente. Os custos do tratamento, como os medicamentos e os procedimentos de laboratório, são divididos entre as duas mulheres. Essa colaboração financeira mútua alivia o peso econômico, tornando a jornada para a maternidade viável para mais pessoas.

O Processo da Fertilização In Vitro (FIV) com Óvulos Doados
A Fertilização In Vitro (FIV) com óvulos doados é um processo cuidadosamente orquestrado. Primeiramente, a receptora passa por uma preparação do endométrio, a camada interna do útero, para que ele esteja receptivo à implantação do embrião. Paralelamente, os óvulos da doadora são coletados após um processo de estimulação ovariana. Esses óvulos são então fertilizados em laboratório com os espermatozoides do parceiro da receptora (ou de um doador, em casos específicos).
Os embriões resultantes são cultivados por alguns dias em observação. Quando atingem o estágio ideal, um ou mais embriões são transferidos para o útero da receptora. O acompanhamento médico é contínuo, e após cerca de duas semanas, um teste de gravidez confirma o sucesso do procedimento. Todo o processo é monitorado de perto por uma equipe especializada para otimizar as chances de uma gestação saudável.
Custos Envolvidos na Ovodoação e FIV no Brasil
O investimento em uma FIV com óvulos doados no Brasil pode variar consideravelmente, mas, em geral, situa-se na faixa de R$ 35.000 a R$ 60.000. Este valor engloba diversas etapas cruciais do processo. Inclui a avaliação e preparação da doadora, a estimulação ovariana, a coleta dos óvulos, a fertilização em laboratório, o cultivo dos embriões e a transferência para a receptora.
É importante notar que este custo é uma estimativa e pode ser influenciado por fatores como a clínica escolhida, a complexidade do caso, a necessidade de procedimentos adicionais e a inclusão de custos como medicamentos, exames complementares e possíveis taxas de congelamento de embriões. Na doação compartilhada, esses custos são divididos, tornando o tratamento mais acessível.

A Influência da Epigenética na Doação de Óvulos
Um aspecto fascinante da ovodoação é o papel da epigenética. Ela demonstra como o ambiente uterino da gestante pode influenciar a expressão dos genes herdados do óvulo doado. Isso significa que, embora a criança receba o material genético do óvulo e do espermatozoide, a gestação em si pode modular como esses genes se manifestam. Fatores como a nutrição, o estresse e outros aspectos do ambiente gestacional podem ter um impacto sutil, mas significativo, no desenvolvimento do bebê.
Essa compreensão é um lembrete poderoso de que a maternidade vai além da genética. O cuidado, o ambiente e o amor oferecidos durante a gestação e após o nascimento desempenham um papel fundamental na formação do indivíduo. A epigenética adiciona uma camada de profundidade à relação entre a mãe que gesta e o filho que se desenvolve em seu ventre.

Maternidade Legal e Anonimato na Ovodoação
No Brasil, a lei é clara: a maternidade legal é definida por quem gesta e dá à luz. Isso significa que a mãe da criança concebida por ovodoação é a mulher que passou pela gravidez e pelo parto, independentemente de ter doado o óvulo. Essa regulamentação garante segurança jurídica e emocional para a família que constrói sua história através da reprodução assistida.
O anonimato entre doadora e receptora é um princípio legal inegociável. A identidade de ambas as partes é mantida em sigilo, protegendo a privacidade e evitando potenciais conflitos ou expectativas futuras. A doação é um ato de generosidade, e a manutenção do anonimato assegura que o foco permaneça no bem-estar da criança e na formação da nova família.

O Caminho para a Maternidade em 2026: Vale a Pena?
A decisão de seguir o caminho da ovodoação em 2026 é profundamente pessoal e, para muitas, representa a realização de um sonho há muito acalentado. O investimento, tanto financeiro quanto emocional, é considerável, mas os resultados podem ser transformadores. A possibilidade de vivenciar a gravidez, o parto e a criação de um filho é, sem dúvida, um dos maiores presentes que a medicina reprodutiva pode oferecer.
Considerando a regulamentação robusta, o avanço das técnicas de reprodução assistida e o suporte oferecido pelas clínicas especializadas, a ovodoação se consolida como uma via segura e eficaz para a maternidade. O acompanhamento médico e psicológico durante todo o processo é fundamental para garantir que a jornada seja o mais tranquila e bem-sucedida possível, culminando na alegria de formar uma família.
Dicas Extras
- Priorize a saúde: Antes de pensar em doar ou receber, cuide da sua saúde física e mental. Uma doação de óvulos bem-sucedida começa com você se sentindo bem.
- Busque informação de qualidade: Não se baseie apenas em conversas. Procure clínicas de reprodução assistida com boa reputação e converse com especialistas. O processo de reprodução assistida é complexo e exige conhecimento.
- Entenda os aspectos emocionais: Tanto para quem doa quanto para quem recebe, a jornada emocional é intensa. Esteja preparada para lidar com sentimentos diversos e busque apoio se necessário.
- Planejamento financeiro: A fertilização in vitro (FIV) com óvulos doados tem um custo. Pesquise sobre a doação compartilhada, que pode ajudar a reduzir despesas.
- Conheça a regulamentação: Familiarize-se com as normas do Conselho Federal de Medicina (CFM). Saber seus direitos e deveres é fundamental.
Dúvidas Frequentes
Quem pode doar óvulos no Brasil?
No Brasil, podem doar óvulos mulheres entre 18 e 35 anos, com boa saúde geral e reserva ovariana adequada. É preciso passar por uma avaliação médica completa para garantir que a doação seja segura para a doadora e para a futura criança. A doação de óvulos é um ato altruísta e anônimo.
Qual o custo da doação de óvulos para FIV?
O custo médio de uma fertilização in vitro (FIV) com óvulos doados no Brasil pode variar entre R$ 35.000 e R$ 60.000. Esse valor inclui os procedimentos médicos, exames e medicamentos. A doação compartilhada é uma opção para dividir esses custos.
A mãe legal da criança é quem doa o óvulo?
Não. No Brasil, a legislação determina que a mãe da criança é a mulher que a gesta e dá à luz. A origem genética do óvulo não altera o vínculo legal e materno. Este é um ponto importante para entender a maternidade legal.
Como funciona a doação de óvulos para casais homoafetivos?
Casais homoafetivos masculinos podem ter filhos através da doação de óvulos combinada com um útero de substituição (barriga de aluguel). Os óvulos podem vir de uma doadora anônima ou de uma amiga/parente, e o embrião é gerado com o espermatozoide de um dos parceiros.
Rumo à Maternidade em 2026
A jornada da maternidade por meio da doação de óvulos é repleta de esperança e informação. Compreender os requisitos, os processos e os aspectos legais é o primeiro passo para realizar esse sonho. Lembre-se que o caminho pode envolver reflexões sobre os aspectos emocionais da ovodoação e a busca por alternativas à doação de óvulos, caso seja necessário. A ciência e a medicina estão avançando, e 2026 pode ser o ano em que seu sonho se torna realidade.

